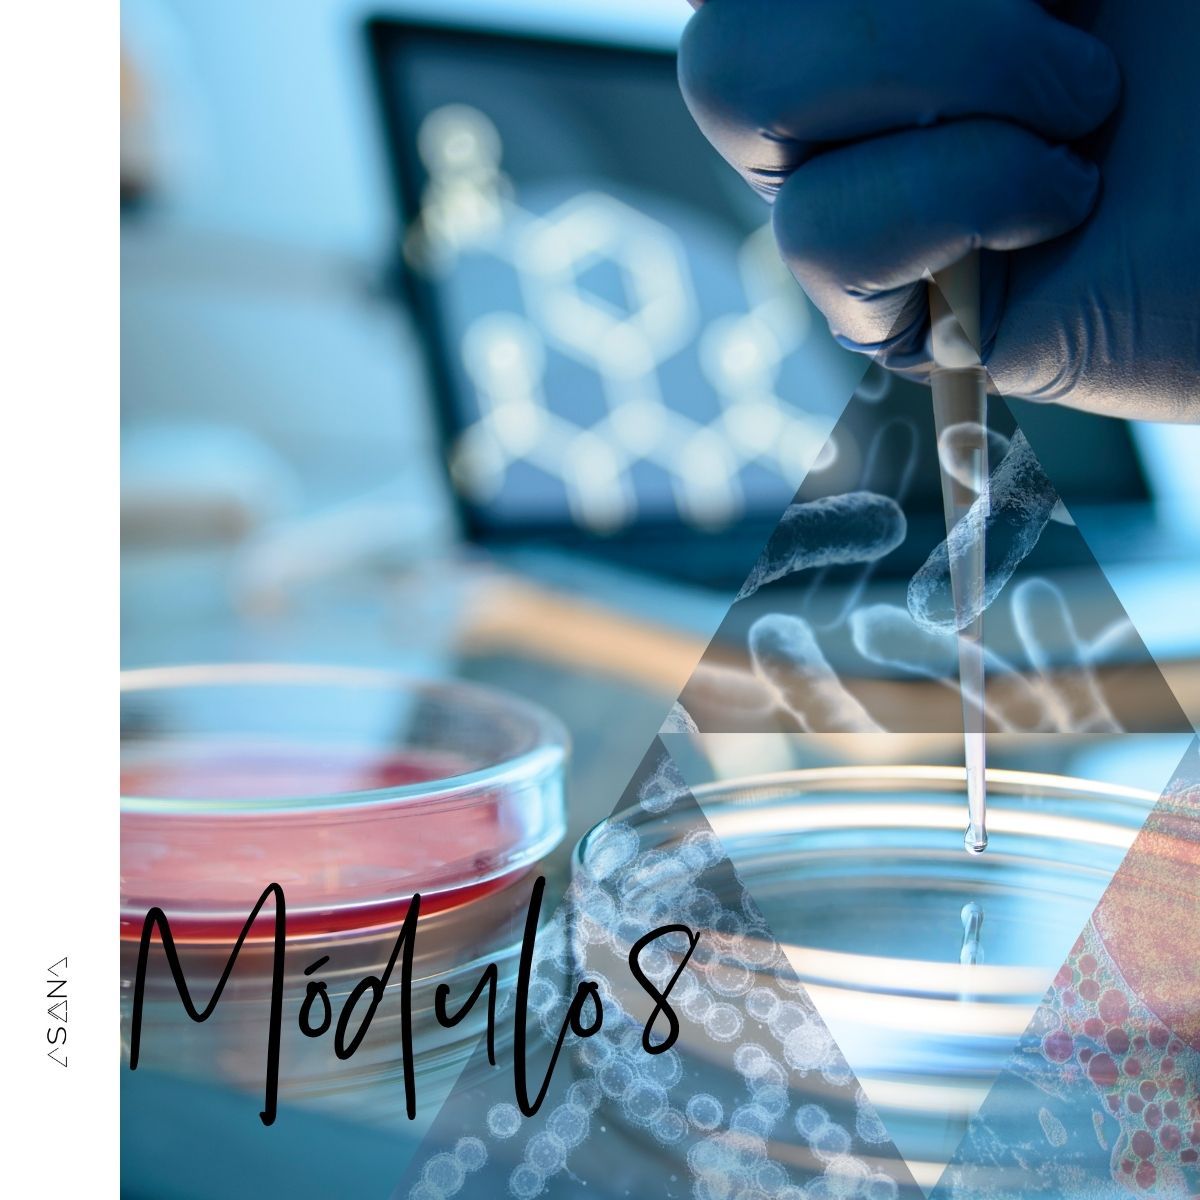

VPBS: Vientre plano y barriga sana.
Mejora tu digestión y di adiós a la inflamación.
¿De qué se trata?
El programa grupal de 8 semanas que te ayudará a deshacerte de la hinchazón abdominal y tener las mejores digestiones de tu vida.
Y no solo eso, puesto que un sistema digestivo en mal estado impacta en todo el resto de sistemas del cuerpo. Verás mejorar muchos otros aspectos de tu vida y tu salud al seguir este plan.
No es un programa más de alimentación, te lo prometo.
Si has hecho mil dietas y nada acaba de mejorar tus síntomas, quizá es que debas mirar más allá de la comida. Y en eso, puedo ayudarte! ;)
Me uno a VPBSIRÉ AL GRANO
TE MUERES DE GANAS POR...
- Tener el vientre plano.
- Deshacerte del ardor o el reflujo.
- Ir al baño cada día...
- O no ir tanto.
- Olvidarte de los gases.
- Y de que estás haciendo la digestión.
PERO LA REALIDAD ES OTRA:
- Estás constantemente preocupada por qué comer.
- Da igual lo que hagas que acabas el día hinchada como un globo.
- Los ardores no te dan tregua.
- Vas metiendo tripa todo el día.
- Los incómodos gases no te dejan vivir en paz.
- Y lo peor, tienes dolor.
Según estudios internacionales se estima que hasta el 40 % de la población podría sufrir un proceso digestivo patológico y crónico (de larga duración).
Y ESTO NO PUEDE SER. ¿LE PONEMOS REMEDIO?
Comprendo que creas que lo tuyo no tiene solución.
Nos han hecho creer que la alimentación es lo único importante en los problemas digestivos... y tú ya has probado de todo. ¡Pero nada más lejos!
En el vídeo te explico la importancia de atender otras cuestiones (tiene subtítulos).

Te presento
Vientre Plano y Barriga Sana
En este programa grupal voy a proporcionarte toda la información que doy en mis consultas 1 a 1, pero con mucho más detalle. Vas a entender el por qué de cada recomendación y vas a ver tan claro el beneficio, que no te quedará más remedio que llevar a cabo los cambios que te propongo.
Incluye:

Proceso probado
con cientos de pacientes a lo largo de mi camino en el mundo de la salud.

Instrucciones paso a paso
para recuperar el funcionamiento normal de tu sistema digestivo.

Comunidad privada de apoyo
en Telegram. Para que te sientas acompañada en todo momento por mí y por tus compañeras de viaje.

Acceso de por vida
Podrás consultar cualquier módulo del curso siempre que te haga falta.
He aparecido en


Qué encontrarás en el programa
Módulo 01
La digestión.
Para saber qué está fallando primero debemos conocer cómo es un proceso digestivo óptimo y qué aspectos pueden influir en él.
Módulo 02
Problemas habituales.
Un repaso por los problemas y síntomas más habituales que podemos encontrar cuando hablamos de sistema digestivo.
Habitos a implementar y suplementos recomendados en cada caso.
Incluye el protocolo: Reset microbiota!
Módulo 03
Alimentación antiinflamatoria.
Qué alimentos debemos potenciar y cuáles debemos reducir.
Módulo 04
Ritmos circadianos.
La luz y la oscuridad influyen tanto o más que la alimentación cuando hablamos del sistema digestivo.
Aprenderás qué espera nuestro cuerpo obtener y cómo proporcionárselo.
Módulo 05
Estrés y digestión.
Seguramente no es ninguna sorpresa que el estrés impacta en la digestión, ¿verdad? Vamos a indagar en eso que llamamos estrés y vamos a entender por qué es necesario y aprender técnicas para gestionarlo.
Módule 06
Tóxicos y su relación con la digestión.
En el mundo actual existen numerosas sustancias que no existían hace pocas decenas o cientos de años. Y esto tiene un impacto enorme en la salud, incluida la digestiva.
Repasaremos los tóxicos que más impactan en nuestra salud y aprenderás a hacer mejores elecciones a la hora de la compra.
Módulo 07
Fermentados.
Nos hemos olvidado de estos superalimentos.
Tendrás una guía sobre los más adecuados y cómo introducirlos en el contexto de una alimentación actual.
Módulo 08
Pruebas complementarias.
Aunque en mi prática clínica me apoyo principalmente en la clínica (signos y síntomas del paciente) en ocasiones es necesaria pedir alguna prueba.
En este módulo te explicaré las que se utilizan para detectar celiaquía, SIBO, candidiasis, intolerancias...
La experiencia de algunas personas que he acompañado
"El primer mes en muchos años sin tomar pastillas. Además, hacía años que no llegaba a este peso, 5kg he perdido comiendo sano. Y lo mejor de todo: desde que fui a tu consulta se acabaron las diarreas y me encuentro super bien. Eternamente agradecida."
Leire (con endometriosis e intestino irritable).
"¡No tomo nada ya para el asma y respiro mejor que nunca! Desde hace un año nada de nada.
¡Me curé! Gracias por los consejos que me diste. Ahora estoy mucho más sano.
Oscar (practicante de triathlon con asma)
Comienza tu nueva vida.
Sintiéndote ligera y llena de energía.
Olvídate de ir metiendo tripa por la vida, de vivir preocupada por si esto o aquello te sentará bien, de vivir pendiente de tener un baño a mano. En resumen, olvídate de tus digestiones y empieza a vivir una vida normal.
Inscribirse
Puedes hacer el programa por tu cuenta o con mi ayuda
Elige lo que mejor te convenga.
Además
Incluidos con este programa están los siguientes Bonus.

Masterclass "Aprende los trucos para cocinar en pocas horas el menú de toda la semana".
by Canela y coco.

Cómo organizar la compra mensual.
by Marina Ribas.

Aprende a leer etiquetas.
En esta miniclase te explicaré en qué te tienes que fijar al comprar productos envasados y cómo escoger un buen procesado.
¡Hola! Soy Ainhoa.
Y voy a acompañarte en este camino hacia tu bienestar.
Durante años sufrí problemas digestivos y ahora me dedico a ayudar a las personas a mejorar su equilibrio digestivo y hormonal con cambios en la alimentación y el estilo de vida.
Después de estudiar dietética, fisioterapia, osteopatía, PNI y 800 cursos más...
He creado un método propio para cuidar la salud digestiva que va mucho más allá de qué alimentos comer y cuáles mejor evitar.
La última gran herramienta que he descubierto y aplico en mí y en mis pacientes es la biología cuántica. Porque lo que ocurre a nivel subatómico, es lo que se percibe después a nivel externo.
Probablemente ya me hayas visto "recogiendo electrones" con los pies descalzos en la tierra en mi Instagram, ¿verdad?
Si quieres que te explique de primera mano como estos detalles pueden ayudarte a mejorar tu salud, únete al programa.
Quiero sanar mi inflamación de una vez
No es imprescindible que un terapeuta haya pasado por lo mismo que tú para guiarte, pero siempre ayuda a entender mejor a las personas que acompañas. Con este programa quiero ahorrarte años de vueltas y errores que yo cometí. .
ES LO QUE ESTABAS ESPERANDO.
Vídeo de Edu
Esto es lo que él consiguió siguiendo mis consejos.
Algunos testimonios más
En tres meses, tú podrías sentirte igual de bien.
"Tras dar muchas vueltas con diferentes profesionales para mis problemasdigestivos y de ansiedad empecé el tratamiento con Ainhoa y he podido recuperar mi salud. Aunque es un camino largo, ella me ha ayudado con profesionalidad, cariño y empatía, tiene mucho conocimiento sobre transtornos digestivos y lo transmite desde lahumildad."
Ane Gurrutxaga
"Mi calidad de vida en términos de salud digestiva se divide en dos: antes y después de Ainhoa. Llegué a ella por recomendación de una amiga y de ser testigo de cómo mejoró su salud en poco tiempo. En ese momento entendí que no podía ser normal vivir 3 días de la semana con dolores fuertes de panza, los otros 4 con molestias y los 7 con hinchazón, malas digestiones, erutadera, exceso de gases, reflujo... Había consultado varias veces con el médico, especialmente por los dolores, pero la respuesta era simpre la misma: cólon irritable, estrés,… pero ninguna propuesta para resolverlo. Lo peor era que no podía disfrutar la comida, porque todo me sentaba mal.
Cuando inicié el tratamiento con Ainhoa, me empezó a cambiar la vida de tal manera, que hasta mi pareja lo notó muy ponto. Los síntomas simplemente desaparecieron. Me empecé a sentir tan bien en mi cuerpo, que el cambio de alimentación no resultó tan dificil: cuando sabes lo mal que la pasas con ciertos grupos de alimentos, no es dificil reducirlos a excepeciones sociales o dejarlos por completo.
Lo que más me ha sorprendido es que también desaparecieron una serie de síntomas que no había relacionado con la salud intestinal, como los dolores articulares en las manos, el acné premenstrual y los cólicos fuertes en la menstruación.
Eso sí, es un proceso que exige disciplina, organización y sobre todo, constancia, pero los resultados valen tanto la pena, que eso hace que cueste menos. Lo que más valoro es que he aprendido mucho sobre mi propio cuerpo y la relación con el alimento, los ritmos circadianos y el estrés. Ahora soy más dueña de mi salud y disfruto comer bien. "
Adriana Orjuela
¿Estás lista para transformar tu salud?
SIGUE ESTOS 3 SENCILLOS PASOS

Únete al curso

Comprométete con el cambio

Disfruta de tu nueva vida
Las inscripciones se cierran en:
00
DÍAS
00
HORAS
00
MINS
00
SEGS
Preguntas frecuentes
Todas tus dudas contestadas aquí
¿Cómo son las 4 sesiones que incluye la opción con tu acompañamiento?
¿Qué tipo de cosas puedo preguntar en el grupo de Telegram?
¿Este programa es solo para mujeres?
¿Cuánto tiempo le tengo que dedicar?
Me sirve si tengo....
Yo ya como bien.
Con el estrés no se puede luchar...
Es caro o no puedo pagarlo ahora
Yo ya hago todo lo que comentas en el curso. Por ejemplo, tengo horarios regulares, no trasnocho y uso dispositivos para poner el móvil en rojo por la noche.
La llave hacia un futuro mejor está aquí.
Comencemos este camino juntas. Estoy segura de que no te arrepentirás.
Inscríbete